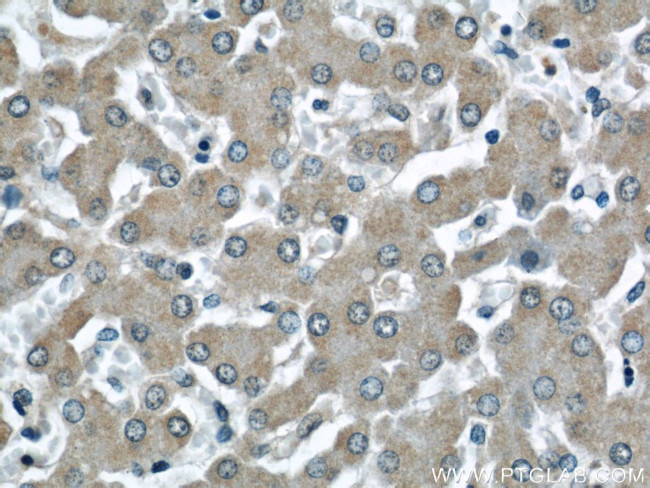
NUDT9 Antibody in Immunohistochemistry (Paraffin) (IHC (P))

Search
Proteintech
NUDT9 Polyclonal Antibody
{{$productOrderCtrl.translations['antibody.pdp.commerceCard.promotion.promotions']}}
{{$productOrderCtrl.translations['antibody.pdp.commerceCard.promotion.viewpromo']}}
{{$productOrderCtrl.translations['antibody.pdp.commerceCard.promotion.promocode']}}: {{promo.promoCode}} {{promo.promoTitle}} {{promo.promoDescription}}. {{$productOrderCtrl.translations['antibody.pdp.commerceCard.promotion.learnmore']}}
产品信息
15068-1-AP
种属反应
已发表种属
宿主/亚型
分类
类型
抗原
偶联物
形式
浓度
规格
纯化类型
保存液
内含物
保存条件
运输条件
产品详细信息
Immunogen sequence: RCRGIQAFR NSFSSSWFHL NTNVMSGSNG SKENSHNKAR TSPYPGSKVE RSQVPNEKVG WLVEWQDYKP VEYTAVSVLA GPRWADPQIS ESNFSPKFNE KDGHVERKSK NGLYEIENGR PRNPAGRTGL VGRGLLGRWG PNHAADPIIT RWKRDSSGNK IMHPVSGKHI LQFVAIKRKD CGEWAIPGGM VDPGEKISAT LKREFGEEAL NSLQKTSAEK REIEEKLHKL FSQDHLVIYK GYVDDPRNTD NAWMETEAVN YHDETGEIMD NLMLEAGDDA GKVKWVDIND KLKLYASHSQ FIKLVAEKRD AHWSEDSEAD CHAL (28-350 aa encoded by BC000542)
靶标信息
YBX1 binds to splice sites in pre-mRNA and regulates splice site selection. This protein binds and stabilizes cytoplasmic mRNA and contributes to the regulation of translation by modulating the interaction between the mRNA and eukaryotic initiation factors. It binds to promoters that contain a Y-box (5'-CTGATTGGCCAA-3'), such as HLA class II genes. It regulates the transcription of numerous genes and promotes separation of DNA strands that contain mismatches or are modified by cisplatin. It has endonucleolytic activity and can introduce nicks or breaks into double-stranded DNA (in vitro), and it may play a role in DNA repair.
仅用于科研。不用于诊断过程。未经明确授权不得转售。
生物信息学
蛋白别名: Adenosine diphosphoribose pyrophosphatase; ADP-ribose diphosphatase; ADP-ribose phosphohydrolase; ADP-ribose pyrophosphatase; ADP-ribose pyrophosphatase, mitochondrial; ADP-ribose pyrosphosphatase NUDT9; ADPR-PPase; contains a nudix (mutT) motif; member of the nudix (MutT) hydrolase family; nucleoside diphosphate linked moiety X-type motif 9; Nucleoside diphosphate-linked moiety X motif 9; nudix (nucleoside diphosphate linked moiety X)-type motif 9; nudix -type motif 9; Nudix motif 9; nudix-type motif 9; unnamed protein product
基因别名: 1190002C07Rik; ADPR-PPase; AI462474; NUDT10; NUDT9; PSEC0099; UNQ3012/PRO9771
UniProt ID: (Human) Q9BW91, (Rat) Q5XIG0, (Mouse) Q8BVU5
Entrez Gene ID: (Human) 53343, (Rat) 305149, (Mouse) 74167